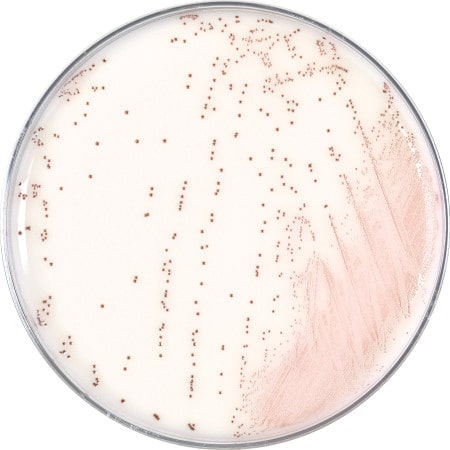

Hardy Diagnostics, 805-346-2766
Thursday, May 28, 2026, 1:00–2:00 PM ET
This session is designed to improve understanding and application of recent updates to synoptic pathology reporting protocols such as the latest Reporting Template for Reporting Results of Biomarker Testing of Specimens from Patients with Carcinoma of the Breast. These changes reflect evolving clinical guidelines that directly influence diagnostic accuracy and treatment selection in breast cancer care.
Webinar presenters Thaer Khoury, MD, FCAP, Chair, Pathology and Laboratory Medicine, Roswell Park Comprehensive Cancer Center, and Colin Murphy, CEO of mTuitive.
Moderated by: Bob McGonnagle, Publisher, CAP TODAY
Tuesday, June 9, 2026, 1:00–2:00 PM ET
In this webinar, we will examine how immune recognition after allogeneic HCT can influence leukemia relapse and disease progression. The session will highlight the clinical relevance of HLA loss of heterozygosity (LOH), approaches used for its detection, and how LOH findings may support transplant strategies, including considerations for donor selection in subsequent transplantation.
Webinar presenter Alberto Cardoso Martins Lima, PhD, Clinical consulting scientist in histocompatibility,
specializing in allogeneic hematopoietic cell transplantation (HCT) at IGEN/AFIP São Paulo and CHC/UFPR in Curitiba, Brazil
Moderated by: Bob McGonnagle, Publisher, CAP TODAY
Wednesday, June 24, 2026, 12:00–1:00 PM ET
Hear an expert discuss the expanded clinical utility of HER2 IHC scoring in metastatic breast cancer and its impact on your practice
Webinar presenter Michelle Shiller, DO, AP, CP, MGP, FACP, Baylor University Medical Center.
Moderated by: Bob McGonnagle, Publisher, CAP TODAY
Hardy Diagnostics, 805-346-2766